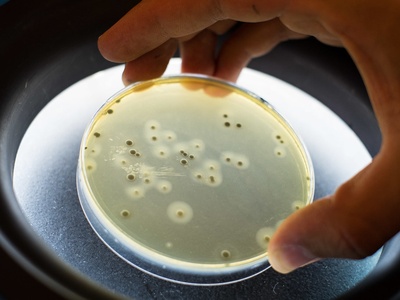
Staphylococcus aureus
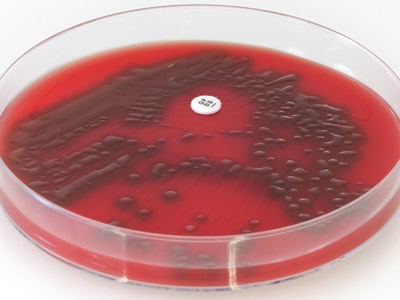
Streptococcus pneumoniae
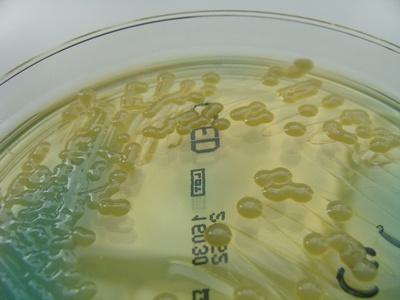
Klebsiella pneumoniae
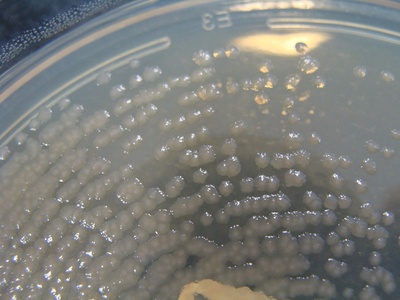
Pseudomonas aeruginosa
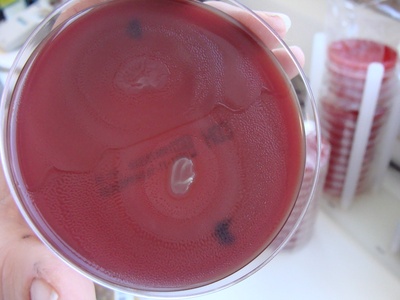
Proteus mirabilis
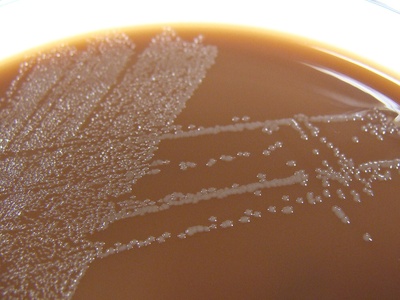
Haemophilus influenzae
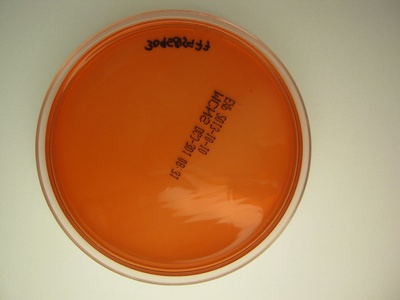
Pasteurella multocida
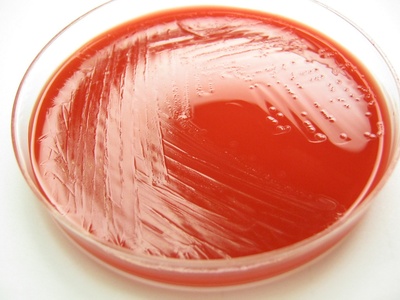
Eikenella corrodens
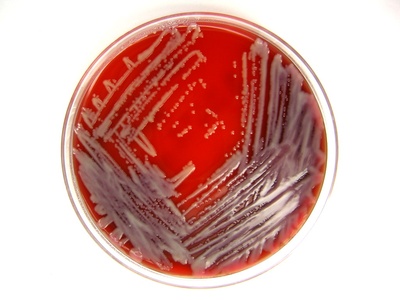
Stenotrophomonas maltophilia
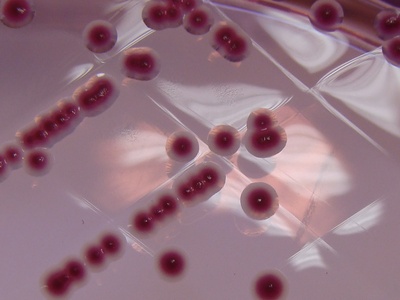
Yersinia enterocolitica

In clinical and public-health settings, having a clear, searchable list of bacterial threats makes it easier to prioritize surveillance, prevention, and treatment. Whether you’re scanning for hospital risks or studying zoonotic transmission, a compact reference saves time and reduces guesswork.
There are 92 Pathogenic Bacteria, ranging from Acinetobacter baumannii to Yersinia pestis. For each entry the columns are Scientific name,Main diseases,Transmission / reservoir, which you’ll find below.
Which bacteria on the list are most often linked to hospital-acquired infections?
Common hospital-associated pathogens include Acinetobacter baumannii, Pseudomonas aeruginosa, Klebsiella pneumoniae and certain strains of Staphylococcus aureus; the list shows their main diseases and typical reservoirs so you can target infection-control measures like hand hygiene, environmental cleaning, and antimicrobial stewardship.
How can I use this list to assess local public health risk?
Use the columns to filter by transmission route and disease severity: prioritize organisms with airborne or vector-borne spread and high morbidity, compare against local surveillance data, and consult clinical labs for confirmation—this helps convert the list into practical actions for prevention and reporting.
Pathogenic Bacteria
| Name | Scientific name | Main diseases | Transmission / reservoir |
|---|---|---|---|
| Staphylococcus aureus | Staphylococcus aureus | Skin infections, abscesses, bacteremia, endocarditis, pneumonia | Skin contact, respiratory droplets, nasal carriage |
| MRSA (methicillin-resistant Staph. aureus) | Staphylococcus aureus (methicillin-resistant strains) | Skin/soft tissue infections, bacteremia, pneumonia | Person-to-person contact; human reservoir |
| Streptococcus pyogenes (Group A Strep) | Streptococcus pyogenes | Strep throat, skin infections, cellulitis, necrotizing fasciitis, rheumatic fever | Respiratory droplets, skin contact; human reservoir |
| Streptococcus pneumoniae | Streptococcus pneumoniae | Pneumonia, otitis media, meningitis, bacteremia | Respiratory droplets; human nasopharynx reservoir |
| Streptococcus agalactiae (Group B Strep) | Streptococcus agalactiae | Neonatal sepsis, meningitis, maternal postpartum infections | Maternal genital tract carriage; perinatal transmission |
| Enterococcus faecalis | Enterococcus faecalis | Urinary tract infection, bacteremia, endocarditis | Gut commensal; fecal-oral, device-associated |
| VRE (vancomycin-resistant Enterococcus) | Enterococcus faecium/faecalis (vancomycin-resistant strains) | Bacteremia, UTI, wound infections, endocarditis | Fecal carriage; healthcare transmission |
| Escherichia coli (pathogenic strains) | Escherichia coli | Urinary tract infections, sepsis, intra-abdominal infections | Fecal-oral, endogenous gut reservoir; contaminated food/water |
| E. coli O157:H7 | Escherichia coli O157:H7 | Hemorrhagic colitis, hemolytic uremic syndrome (HUS) | Contaminated food, undercooked beef, fecal-oral; animal reservoirs |
| Klebsiella pneumoniae | Klebsiella pneumoniae | Pneumonia, UTI, bacteremia, liver abscess | Respiratory droplets, fecal carriage; healthcare reservoirs |
| Pseudomonas aeruginosa | Pseudomonas aeruginosa | Hospital pneumonia, wound infections, otitis, bacteremia | Moist environments, water sources; opportunistic |
| Acinetobacter baumannii | Acinetobacter baumannii | Ventilator-associated pneumonia, wound infections, bacteremia | Hospital surfaces, devices; opportunistic |
| Enterobacter cloacae complex | Enterobacter cloacae complex | UTI, bacteremia, pneumonia, device infections | Gut flora, healthcare-associated transmission |
| Proteus mirabilis | Proteus mirabilis | UTI, kidney stones, wound infections | Fecal-oral, urinary tract colonization |
| Serratia marcescens | Serratia marcescens | UTI, wound infections, pneumonia, bacteremia | Healthcare-associated, contaminated solutions/devices |
| Neisseria meningitidis | Neisseria meningitidis | Meningitis, meningococcemia, septicemia | Respiratory droplets; human nasopharynx reservoir |
| Neisseria gonorrhoeae | Neisseria gonorrhoeae | Gonorrhea: urethritis, cervicitis, PID, disseminated infection | Sexual transmission; human-only reservoir |
| Haemophilus influenzae | Haemophilus influenzae (including type b) | Pneumonia, otitis media, meningitis (Hib) | Respiratory droplets; human nasopharynx |
| Bordetella pertussis | Bordetella pertussis | Pertussis (whooping cough) | Respiratory droplets; human reservoir |
| Legionella pneumophila | Legionella pneumophila | Legionnaires’ disease (pneumonia), Pontiac fever | Aerosolized water, cooling towers, amoebae reservoir |
| Mycobacterium tuberculosis | Mycobacterium tuberculosis | Pulmonary tuberculosis, extrapulmonary TB | Airborne droplets; human reservoir |
| Mycobacterium avium complex (MAC) | Mycobacterium avium complex (M. avium/M. intracellulare) | Pulmonary disease, disseminated infection in HIV | Environmental (water, soil); opportunistic |
| Listeria monocytogenes | Listeria monocytogenes | Neonatal sepsis, meningitis, gastroenteritis | Contaminated food (dairy, deli meats); environmental reservoirs |
| Salmonella enterica serovar Typhi | Salmonella enterica serovar Typhi (S. Typhi) | Typhoid fever (systemic febrile illness) | Fecal-oral; human carrier reservoir |
| Non-typhoidal Salmonella | Salmonella enterica (non-typhi) | Gastroenteritis, sometimes bacteremia | Contaminated food (poultry, eggs); animal reservoirs |
| Shigella species | Shigella sonnei, flexneri, dysenteriae | Bacillary dysentery, bloody diarrhea, fever | Fecal-oral, person-to-person; low infectious dose |
| Vibrio cholerae | Vibrio cholerae (O1/O139) | Cholera: profuse watery diarrhea, dehydration | Contaminated water/food; aquatic reservoirs |
| Vibrio vulnificus | Vibrio vulnificus | Severe wound infection, septicemia (shellfish-associated) | Contaminated seawater, raw shellfish; marine reservoir |
| Campylobacter jejuni | Campylobacter jejuni | Bacterial gastroenteritis, Guillain–Barré syndrome risk | Contaminated poultry, unpasteurized milk; animal reservoirs |
| Helicobacter pylori | Helicobacter pylori | Gastritis, peptic ulcer disease, gastric cancer risk | Oral-oral or fecal-oral; human reservoir |
| Clostridioides difficile | Clostridioides difficile | Antibiotic-associated colitis, pseudomembranous colitis | Fecal-oral, spore contamination in healthcare |
| Clostridium perfringens | Clostridium perfringens | Gas gangrene, food poisoning, soft tissue infection | Soil, contaminated food, wound contamination |
| Clostridium tetani | Clostridium tetani | Tetanus: muscle rigidity, spasms | Environmental spores in soil; wound contamination |
| Clostridium botulinum | Clostridium botulinum | Botulism: flaccid paralysis, intoxication | Contaminated food, wounds, infant intestinal colonization |
| Corynebacterium diphtheriae | Corynebacterium diphtheriae | Diphtheria: pharyngitis, pseudomembrane, myocarditis | Respiratory droplets; human reservoir |
| Bacillus anthracis | Bacillus anthracis | Cutaneous, inhalational, gastrointestinal anthrax | Spores from contaminated animals/products; zoonotic |
| Yersinia pestis | Yersinia pestis | Plague: bubonic, septicemic, pneumonic | Flea bites from rodents; zoonotic reservoirs |
| Francisella tularensis | Francisella tularensis | Tularemia: ulceroglandular, pneumonic disease | Exposure to infected animals, ticks; zoonotic reservoirs |
| Brucella species | Brucella melitensis, abortus | Brucellosis: fever, malaise, osteoarticular disease | Unpasteurized dairy, occupational exposure; animal reservoirs |
| Treponema pallidum | Treponema pallidum | Syphilis: primary chancre, secondary rash, tertiary complications | Sexual contact, vertical transmission |
| Borrelia burgdorferi | Borrelia burgdorferi | Lyme disease: erythema migrans, arthritis, neurologic | Ixodes tick bite; animal reservoirs |
| Rickettsia rickettsii | Rickettsia rickettsii | Rocky Mountain spotted fever (fever, rash) | Tick-borne; zoonotic reservoirs |
| Ehrlichia chaffeensis | Ehrlichia chaffeensis | Human monocytic ehrlichiosis (fever, cytopenias) | Tick-borne; animal reservoirs |
| Chlamydia trachomatis | Chlamydia trachomatis | Cervicitis, urethritis, PID, trachoma, neonatal conjunctivitis | Sexual contact, eye-to-eye (trachoma); human reservoir |
| Chlamydia pneumoniae | Chlamydia pneumoniae | Atypical pneumonia, bronchitis | Respiratory droplets; human reservoir |
| Mycoplasma pneumoniae | Mycoplasma pneumoniae | Atypical (“walking”) pneumonia, bronchitis | Respiratory droplets; human reservoir |
| Mycoplasma genitalium | Mycoplasma genitalium | Urethritis, cervicitis, PID | Sexual transmission; human reservoir |
| Ureaplasma urealyticum | Ureaplasma urealyticum | Urethritis, neonatal disease, chorioamnionitis | Sexual transmission, maternal genital tract |
| Bacteroides fragilis | Bacteroides fragilis | Intra-abdominal abscess, bacteremia | Gut commensal; endogenous translocation |
| Gardnerella vaginalis | Gardnerella vaginalis | Bacterial vaginosis | Vaginal microbiota imbalance; sexual factors |
| Actinomyces israelii | Actinomyces israelii | Actinomycosis: cervicofacial, thoracic, abdominal abscesses | Oral mucosa, endogenous; dental procedures |
| Nocardia asteroides complex | Nocardia asteroides complex | Pulmonary disease, brain abscesses, cutaneous infection | Soil exposure, inhalation, trauma |
| Pasteurella multocida | Pasteurella multocida | Animal bite wound infection, cellulitis | Animal bites/scratches (cats, dogs); zoonotic |
| Haemophilus ducreyi | Haemophilus ducreyi | Chancroid (painful genital ulcer) | Sexual transmission; human reservoir |
| Streptococcus anginosus group | Streptococcus anginosus group (S. anginosus, S. constellatus) | Abscesses (brain, liver), bacteremia | Oral/intestinal tract flora; endogenous |
| Streptococcus viridans group | Viridans streptococci (S. sanguinis, S. mutans) | Endocarditis, dental caries, bacteremia | Oral cavity; endogenous |
| Gardnerella vaginalis | Gardnerella vaginalis | Bacterial vaginosis | Vaginal microbiota imbalance; sexual factors |
| Campylobacter fetus | Campylobacter fetus | Invasive bacteremia, fetal loss in pregnancy | Animal reservoirs, contaminated food; zoonotic |
| Klebsiella granulomatis | Klebsiella (Calymmatobacterium) granulomatis | Donovanosis (granuloma inguinale) | Sexual transmission; human reservoir |
| Bordetella parapertussis | Bordetella parapertussis | Pertussis-like illness | Respiratory droplets; human reservoir |
| Gardnerella vaginalis | Gardnerella vaginalis | Bacterial vaginosis | Vaginal microbiota imbalance; sexual factors |
| Streptococcus suis | Streptococcus suis | Meningitis, septicemia (zoonotic) | Pig exposure, occupational; animal reservoir |
| Mycobacterium leprae | Mycobacterium leprae | Leprosy (Hansen disease): skin, nerve disease | Prolonged close contact; human reservoir |
| Enterotoxigenic Bacteroides | Bacteroides spp. (enterotoxigenic strains) | Diarrheal disease, intra-abdominal infections | Fecal-oral, endogenous gut flora |
| Chromobacterium violaceum | Chromobacterium violaceum | Severe sepsis, cutaneous infection (rare) | Environmental water/soil; tropical exposures |
| Leptospira interrogans | Leptospira interrogans (pathogenic spp.) | Leptospirosis: febrile illness, renal/hepatic involvement | Exposure to animal urine-contaminated water; zoonotic |
| Capnocytophaga canimorsus | Capnocytophaga canimorsus | Severe sepsis after dog/cat bites | Dog/cat bites or saliva exposure; animal reservoir |
| Tropheryma whipplei | Tropheryma whipplei | Whipple disease: malabsorption, weight loss, arthritis | Unknown environmental/human reservoir; unclear transmission |
| Eikenella corrodens | Eikenella corrodens | Human bite wound infection, head/neck abscesses | Human bites, oral flora; endogenous |
| Klebsiella oxytoca | Klebsiella oxytoca | UTI, pneumonia, antibiotic-associated colitis | Gut flora, healthcare-associated transmission |
| Providencia stuartii | Providencia stuartii | UTI, catheter-associated infections | Fecal carriage, healthcare settings |
| Sneathia spp. | Sneathia spp. | Adverse pregnancy outcomes, bacterial vaginosis association | Vaginal microbiota; endogenous |
| Eggerthella lenta | Eggerthella lenta | Intra-abdominal, bloodstream infections | Gut microbiota; endogenous |
| Stenotrophomonas maltophilia | Stenotrophomonas maltophilia | Pneumonia, bloodstream infections, catheter-related | Water, hospital environment, medical devices |
| Providencia rettgeri | Providencia rettgeri | UTI, wound infections | Fecal carriage, healthcare-associated |
| Bartonella henselae | Bartonella henselae | Cat scratch disease, bacillary angiomatosis | Cat scratches/bites, flea vectors; animal reservoir |
| Anaplasma phagocytophilum | Anaplasma phagocytophilum | Human granulocytic anaplasmosis (fever, cytopenias) | Tick-borne; animal reservoirs |
| Legionella longbeachae | Legionella longbeachae | Legionella pneumonia (linked to potting mix) | Aerosolized soil/potting mix; environmental reservoir |
| Chryseobacterium meningosepticum | Elizabethkingia meningoseptica | Neonatal meningitis, hospital infections | Environmental water; healthcare-associated |
| Pasteurella canis | Pasteurella canis | Wound infection after dog bite | Dog bite/scratch; animal reservoir |
| Mycobacterium marinum | Mycobacterium marinum | Skin and soft tissue infections from aquatic exposure | Contaminated water, fish tanks; environmental reservoir |
| Yersinia enterocolitica | Yersinia enterocolitica | Gastroenteritis, mesenteric adenitis, reactive arthritis | Contaminated food (pork), animal reservoirs |
| Campylobacter coli | Campylobacter coli | Gastroenteritis | Contaminated food, animal reservoirs |
| Kingella kingae | Kingella kingae | Pediatric osteoarticular infections, endocarditis | Oropharyngeal carriage in children; respiratory spread |
| Enterococcus casseliflavus | Enterococcus casseliflavus | Bacteremia, UTI (rare) | Gut flora; endogenous, healthcare-associated |
| Actinobacillus actinomycetemcomitans | Aggregatibacter actinomycetemcomitans | Aggressive periodontitis, endocarditis | Oral flora; endogenous |
| Coxiella burnetii | Coxiella burnetii | Q fever: febrile illness, endocarditis | Aerosols from farm animals; zoonotic |
| Legionella anisa | Legionella anisa | Legionnaires’-type illness (rare) | Environmental water systems |
| Treponema pertenue | Treponema pertenue | Yaws (skin, bone disease) | Skin-to-skin contact; human reservoir |
| Brucella canis | Brucella canis | Brucellosis (rare in humans) | Contact with infected dogs; zoonotic |
| Corynebacterium jeikeium | Corynebacterium jeikeium | Device-related bloodstream infections, endocarditis | Skin colonization; healthcare-associated |
| Bartonella quintana | Bartonella quintana | Trench fever, endocarditis, chronic bacteremia | Body lice, homeless populations |
Images and Descriptions
Staphylococcus aureus
Common human skin and nasal commensal that causes superficial to life‑threatening invasive infections; notable for toxin-mediated disease and frequent antibiotic resistance complicating therapy.

MRSA (methicillin-resistant Staph. aureus)
Methicillin-resistant strains are important hospital and community pathogens; resistance narrows antibiotic choices and MRSA causes outbreaks, severe invasive disease, and increased healthcare burden.

Streptococcus pyogenes (Group A Strep)
A common cause of pharyngitis and invasive soft tissue infections; post-infectious immune complications (rheumatic fever, glomerulonephritis) and toxin-related severe disease make it clinically significant.
Streptococcus pneumoniae
Leading cause of community-acquired pneumonia and bacterial meningitis; encapsulated strains vary in vaccine coverage and antibiotic resistance patterns affect treatment choices.

Streptococcus agalactiae (Group B Strep)
Colonizes vagina/rectum in many adults; causes severe neonatal disease during childbirth and invasive infections in older adults; screening and intrapartum antibiotics prevent newborn infections.

Enterococcus faecalis
Normal intestinal flora that causes hospital-acquired infections, especially with urinary catheters and prosthetic devices; notable for intrinsic and acquired antibiotic resistance.

VRE (vancomycin-resistant Enterococcus)
Vancomycin-resistant strains complicate treatment of enterococcal infections in hospitals; often associated with prolonged antibiotic exposure and invasive devices.

Escherichia coli (pathogenic strains)
Common gut bacterium with strains causing UTIs, bloodstream and wound infections; some produce toxins or extended-spectrum beta-lactamases that drive clinical concern.

E. coli O157:H7
A shiga-toxin producing strain causing bloody diarrhea and sometimes life-threatening kidney failure (HUS), often linked to foodborne outbreaks and person-to-person spread.
Klebsiella pneumoniae
Encapsulated Gram-negative pathogen causing hospital- and community-acquired infections; some strains carry carbapenemases causing multidrug resistance and severe disease.
Pseudomonas aeruginosa
Opportunistic pathogen thriving in moist niches and devices; causes severe infections in immunocompromised hosts and is notable for intrinsic resistance and biofilm formation.

Acinetobacter baumannii
Environmentally hardy hospital pathogen causing difficult-to-treat infections in ICUs; frequently multidrug-resistant and associated with outbreaks.

Enterobacter cloacae complex
Opportunistic Enterobacter species cause nosocomial infections and can acquire inducible beta-lactamases, complicating antibiotic therapy.
Proteus mirabilis
Motile Gram-negative commonly causing complicated urinary tract infections and struvite stone formation due to urease activity; often associated with catheters.

Serratia marcescens
Opportunistic pathogen causing nosocomial outbreaks; notable for red pigment production and multiple resistance mechanisms.

Neisseria meningitidis
Causes rapid-onset meningitis and systemic sepsis; carriage common, outbreaks in close communities, vaccines target major serogroups.

Neisseria gonorrhoeae
Sexually transmitted bacterium causing mucosal infection with rising antibiotic resistance; can disseminate causing arthritis and systemic illness.
Haemophilus influenzae
Encapsulated type b historically caused severe pediatric meningitis; vaccines have greatly reduced Hib disease; non-typeable strains cause otitis and bronchitis.

Bordetella pertussis
Highly contagious cause of prolonged coughing illness, severe in infants; vaccination prevents disease but waning immunity and outbreaks occur.

Legionella pneumophila
Environmental waterborne bacterium causing severe pneumonia when inhaled from contaminated aerosols; diagnosis often requires specialized tests and environmental control.

Mycobacterium tuberculosis
Obligate pathogen causing chronic pulmonary disease with significant global morbidity; long treatment courses required and drug resistance (MDR/XDR) complicates control.

Mycobacterium avium complex (MAC)
Nontuberculous mycobacteria causing chronic lung disease in vulnerable hosts and disseminated disease in immunocompromised people; requires prolonged combination therapy.

Listeria monocytogenes
Foodborne pathogen able to grow at refrigerator temperatures; causes severe fetal, neonatal, and elderly disease with high morbidity.

Salmonella enterica serovar Typhi
Cause of systemic enteric fever with prolonged bacteremia; transmission via contaminated food/water and chronic carriers; antimicrobial resistance is rising.

Non-typhoidal Salmonella
Common cause of foodborne diarrheal illness; invasive disease occurs in infants, elderly or immunocompromised hosts.

Shigella species
Highly infectious cause of severe, sometimes bloody diarrhea and cramps; outbreaks common in crowded settings and antimicrobial resistance is a clinical challenge.

Vibrio cholerae
Produces cholera toxin causing rapid watery diarrhea and severe dehydration; public health concern in outbreaks with need for rehydration therapy.

Vibrio vulnificus
Causes rapidly progressive wound infections and life-threatening sepsis, especially in patients with liver disease; associated with raw oyster consumption and seawater exposure.

Campylobacter jejuni
A frequent cause of foodborne diarrhea; postinfectious autoimmune sequelae (Guillain–Barré) can occur; commonly produces fever and bloody stools.

Helicobacter pylori
Colonizes stomach lining causing chronic gastritis and ulcers; long-term infection increases gastric cancer risk and requires combination antibiotic therapy for eradication.

Clostridioides difficile
Toxin-producing nosocomial pathogen causing severe antibiotic-associated diarrhea and colitis; spores persist in environment and recurrence is common.

Clostridium perfringens
Anaerobic spore-former causing rapid soft tissue necrosis (myonecrosis) and common foodborne illness from preformed toxins.

Clostridium tetani
Produces neurotoxin causing painful muscle rigidity and spasms; preventable by vaccination and treatable with antitoxin and supportive care.

Clostridium botulinum
Produces potent neurotoxins causing flaccid paralysis; foodborne, wound, and infant forms require antitoxin and supportive respiratory care.

Corynebacterium diphtheriae
Produces toxin causing throat pseudomembrane and systemic complications; rare where vaccination is routine, but severe when it occurs.

Bacillus anthracis
Spore-forming pathogen causing severe disease forms, historically linked to biothreat concerns; cutaneous anthrax most common, inhalational is often fatal without treatment.

Yersinia pestis
Cause of historic pandemics; still causes rural bubonic plague via flea transmission and severe pneumonic plague that can transmit person-to-person.

Francisella tularensis
Highly infectious zoonotic bacterium from rabbits/ticks causing varied clinical syndromes; inhalational tularemia can be severe and requires specific therapy.

Brucella species
Causes chronic febrile illness with bone/joint involvement often from unpasteurized dairy or livestock contact; intracellular organism requiring prolonged therapy.

Treponema pallidum
Spirochete causing multisystem disease over stages; diagnosis with serology and treatable with penicillin, important for congenital infection prevention.

Borrelia burgdorferi
Tick-borne spirochete causing early skin lesion and possible later joint, neurologic, or cardiac involvement; diagnosis often clinical plus serology.

Rickettsia rickettsii
Obligate intracellular bacteria causing febrile illness with rash and potential severe vasculitis; prompt doxycycline therapy critical.

Ehrlichia chaffeensis
Intracellular tick-transmitted pathogen causing febrile illness and hematologic abnormalities, diagnosed by PCR or serology and treated with doxycycline.

Chlamydia trachomatis
Obligate intracellular bacterium causing common sexually transmitted infections and ocular disease; often asymptomatic but causes reproductive complications if untreated.

Chlamydia pneumoniae
Causes community-acquired atypical respiratory infections; diagnosis via serology or PCR and treated with macrolides or doxycycline.

Mycoplasma pneumoniae
Small cell-wall–less bacterium causing mild to moderate atypical pneumonia, common in young adults; lacks a cell wall so beta-lactams are ineffective.

Mycoplasma genitalium
Emerging sexually transmitted pathogen causing persistent urethritis and cervicitis; increasing macrolide resistance complicates treatment.

Ureaplasma urealyticum
Small cell-wall–less organism colonizing genitourinary tract; can cause disease in neonates and contributes to obstetric complications in some settings.

Bacteroides fragilis
Anaerobic gut flora that causes intra-abdominal infections and abscesses; often involved in polymicrobial infections and may be beta-lactamase producing.

Gardnerella vaginalis
Associated with bacterial vaginosis from disrupted vaginal flora; causes discharge and odor and has implications for pregnancy and STI susceptibility.

Actinomyces israelii
Filamentous Gram-positive anaerobe causing chronic draining sinuses often after mucosal disruption; requires prolonged antibiotic therapy and sometimes surgery.

Nocardia asteroides complex
Weakly acid-fast branching rods causing pulmonary and disseminated disease mainly in immunocompromised patients; prolonged combination therapy needed.
Pasteurella multocida
Rapidly causes soft tissue infection after animal bites; clinical history of animal exposure guides early empiric therapy.

Haemophilus ducreyi
Causes sexually transmitted genital ulcers (rare in many regions); diagnosis clinical and by culture or molecular methods in endemic areas.

Streptococcus anginosus group
Part of oral and gut flora prone to cause purulent abscesses and invasive infections, often polymicrobial and requiring drainage plus antibiotics.

Streptococcus viridans group
Common oral commensals that can seed damaged heart valves causing subacute endocarditis; also implicated in dental disease and abscesses.

Gardnerella vaginalis
Associated with bacterial vaginosis from disrupted vaginal flora; causes discharge and odor and has implications for pregnancy and STI susceptibility.

Campylobacter fetus
Less common Campylobacter species causing systemic infections and complications in immunocompromised hosts and pregnant women.

Klebsiella granulomatis
Causes chronic genital ulcers (donovanosis) in endemic regions; diagnosis by Donovan bodies and treatable with antibiotics.

Bordetella parapertussis
Causes milder pertussis-like illness; similar transmission and clinical features but generally less severe than B. pertussis.

Gardnerella vaginalis
Associated with bacterial vaginosis from disrupted vaginal flora; causes discharge and odor and has implications for pregnancy and STI susceptibility.

Streptococcus suis
Zoonotic pathogen causing severe meningitis and sepsis in people with swine exposure; occupational risk for farmers and butchers.

Mycobacterium leprae
Slow-growing obligate pathogen causing chronic skin and peripheral nerve disease; treatable but can cause long-term disability and stigma.

Enterotoxigenic Bacteroides
Certain Bacteroides strains contribute to diarrheal illness and are common players in polymicrobial intra-abdominal infections, often requiring anaerobic coverage.

Chromobacterium violaceum
Rare environmental bacterium causing fulminant sepsis following wound contamination in tropical regions; high mortality without prompt treatment.

Leptospira interrogans
Spirochetal zoonosis causing a spectrum from mild fever to severe multi-organ failure; occupational and recreational exposure risks.

Capnocytophaga canimorsus
Oral commensal of dogs/cats causing fulminant sepsis in asplenic or immunocompromised people after bites or licks; early recognition important.

Tropheryma whipplei
Rare systemic disease caused by intracellular bacterium leading to chronic GI and multi-system symptoms; diagnosis by tissue PCR/biopsy and long-term antibiotics.
Eikenella corrodens
Part of normal oral flora causing infections after human bites or dental procedures; often mixed infections requiring specific antibiotic coverage.

Klebsiella oxytoca
Closely related to K. pneumoniae and implicated in nosocomial infections; can cause antibiotic-associated colitis and carries resistance determinants.

Providencia stuartii
Opportunistic Enterobacterales associated with complicated urinary tract infections and device-related outbreaks, often resistant to multiple antibiotics.

Sneathia spp.
Anaerobic vaginal bacteria associated with preterm birth and adverse pregnancy outcomes; emerging recognition in obstetric infections.

Eggerthella lenta
Anaerobic gut organism intermittently pathogenic in intra-abdominal and bloodstream infections, often in polymicrobial disease and difficult to culture.
Stenotrophomonas maltophilia
Opportunistic Gram-negative environmental pathogen causing hospital infections with intrinsic multi-drug resistance; treatment choices limited.

Providencia rettgeri
Opportunistic pathogen causing complicated UTIs and device-associated infections; capable of antimicrobial resistance that complicates therapy.

Bartonella henselae
Causes localized lymphadenopathy after cat exposure and vascular proliferative disease in immunocompromised people; diagnosed by serology or PCR.

Anaplasma phagocytophilum
Intracellular tick-transmitted pathogen causing febrile illness with hematologic abnormalities; early doxycycline treatment recommended.

Legionella longbeachae
Associated with exposure to contaminated soil and potting compost rather than water systems; causes Legionnaires’-type pneumonia, particularly in gardeners.

Chryseobacterium meningosepticum
Rare but serious cause of neonatal meningitis and nosocomial infections with intrinsic resistance; outbreaks linked to contaminated hospital equipment.

Pasteurella canis
Similar to P. multocida, can cause cellulitis and soft tissue infections following dog-related injuries; early wound management critical.

Mycobacterium marinum
Slow-growing nontuberculous mycobacterium causing chronic skin lesions after minor injuries in aquatic environments; requires prolonged targeted therapy.
Yersinia enterocolitica
Causes diarrheal illness often mistaken for appendicitis in children; can trigger reactive arthritis and is transmitted via contaminated food.

Campylobacter coli
Less common Campylobacter species causing diarrheal disease similar to C. jejuni; foodborne transmission predominates.

Kingella kingae
Common cause of bone and joint infections in young children, often following respiratory colonization; diagnosis benefits from molecular methods.

Enterococcus casseliflavus
Less common enterococcus species that can cause opportunistic infections and carries intrinsic low-level vancomycin resistance in some strains.

Actinobacillus actinomycetemcomitans
Oral pathogen implicated in periodontal disease and occasional endocarditis; associated with dental infections and systemic spread.

Coxiella burnetii
Intracellular pathogen transmitted from livestock causing acute febrile illness and chronic endocarditis; notable for environmental stability and occupational risk.

Legionella anisa
Environmental Legionella species occasionally cause pneumonia similar to L. pneumophila; identification important for source control.

Treponema pertenue
Nonvenereal treponemal disease causing chronic skin and bone lesions in tropical areas; treatable with antibiotics and targeted public health campaigns.

Brucella canis
Dog-associated Brucella species causing febrile illness in people with close canine exposure; less common than livestock-associated species.

Corynebacterium jeikeium
Opportunistic, multidrug-resistant skin commensal causing infections in immunocompromised and device-bearing patients; often needs targeted therapy.

Bartonella quintana
Louse-borne bacterium historically causing trench fever and currently linked to chronic bacteremia and endocarditis in vulnerable populations.









